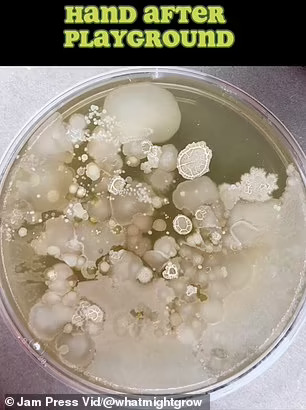

Што навистина живее на рацете на вашето дете по посетата на игралиште: Микробиолог откри илјадници бактерии кои демнат на дланките на децата по само еден час играње
Патувањето до игралиштето е нешто што повеќето деца и родители со нетрпение го очекуваат. Но, новите тестови може да ве предомислат да се упатите кон вашиот локален парк во скоро време. Микробиолог сподели вознемирувачки наоди откако тестираше колку навистина се чисти детските игралишта.
Скролајте надолу за видео

Тим Кол (32) од Јута откри како илјадници бактерии можат да се најдат како демнат на рацете на децата по само еден час на игралиштето.
Г-дин Кол често има лоши вести за гермафобите, откако претходно се најде на насловните страници за споделување шокантни детали за сè, од машина за сушење раце до кујнски мијалници. Микробиологот често ги тестира најчесто користените производи и простори за бактерии.
Па сега Тим дошол до чудното откритие споредувајќи ја количината на бактерии на раката на детето пред и по еден час на игралиштето.
Започнува со тоа што прво ја тестира раката пред да го посети игралиштето. Микробиологот потоа ги покажува предметите на кои си играло детето, вклучително и качување по карпи, лизгање на лизгалки. Еден час подоцна, младото момче ја става раката во друга петриева чинија, која Тим ја однел дома и ја истражувал. Потоа наоѓа илјадници бактериски колонии, како и големи делови од габи.
„Сакав да го направам видеото за игралиштето за да покажам дека бактериите се насекаде. Чувствував дека игралиштето ќе биде забавен начин да го покажам тоа. Со снимањето на ова, сакав да ја истакнам важноста на миењето раце по посетата на места како ова.“, изјави Тим.
Доколку сакате добра акција или пак забегани и жестоки случки само за најхрабрите читатели, тогаш посетете го каналот Жестоко. Предупредување: Содржините може да ве вознемират!

Vasite mali debilcina zatvorete gi doma da ne fatat bakterii oti cicko Soros bara debilcina za da rabotat od 7 nautro do 5 popladne koga ke porasnat. Bravooooo!!!
Otkril Amerika kretenot… Ne samo na igralistata… sekade gi ima! I gi imalo i sekogas ke gi ima! Site sme porasnale so niv, a i sega gi imate na racete.. nisto novo, nisto strasno!! Nekoi “luge” se plateni za vakvi gomna da plasiraat, a drugi da gi sirat!!! Motika… Aj malku mozocite da ne vi se za ukras… Ima mnogu poubavi i popmateni raboti sto mozete da gi objavuvate… Maaalku razmislete so nekoi objavi kakva steta mozete da napravite “nesakajki”… Vie ste poslednata bariera i filter sto nekoe sranje treba da ja pomine pred da bide rasfrlano nasekade…. Pozdrav!
Коментирај анонимно